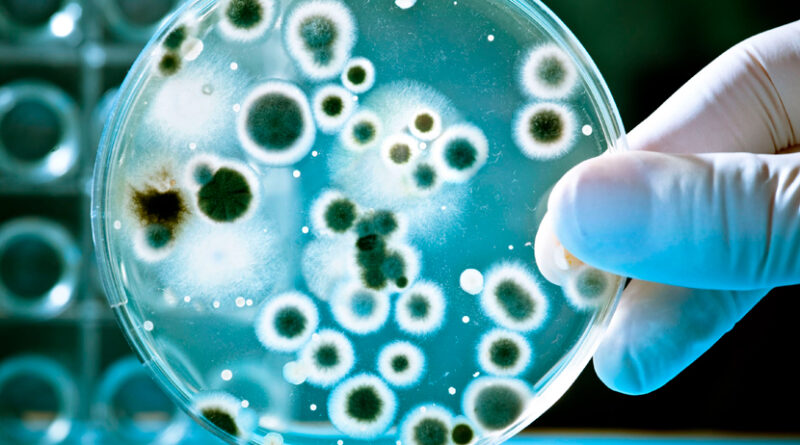

Acogerá Camagüey III Taller Nacional de Parasitología Médica
Camagüey, 8 oct.- Del 12 al 14 de octubre sesionará por segunda ocasión en Camagüey el tercer Taller Nacional de Parasitología Médica Carlos Manuel Finlay Villalvilla in Memoriam con la participación de más de 70 delegados de La Habana, Villa Clara, Santiago de Cuba, Guantánamo, el municipio especial Isla de la Juventud y el territorio agramontino.
En conferencia de prensa el doctor Ubaldo del Risco Barrios, especialista en Microbiología y vicepresidente del Capítulo Provincial dedicado a este campo de la medicina, informó que la cita permitirá intercambiar sobre las parasitosis autóctonas y exóticas para Cuba, la zoonosis parasitaria, la salud pública veterinaria, el control sanitario internacional, el programa de vigilancia y la farmacoterapia antiparasitaria, entre otras temáticas.
Detalló que los diferentes tópicos se presentarán en las modalidades de temas libres, conferencias, videos científicos, carteles y mesas redondas, con una representación de 38 investigadores de la Ciudad de los Tinajones.
En el marco del evento, destacó, se realizará por primera vez un taller nacional de médicos residentes, oportunidad en la que mostrarán casos y revisiones bibliográficas, además de socializar experiencias en su formación como especialistas en Microbiología.
Acerca de los resultados en el campo de la parasitología médica en la provincia, resaltó el posicionamiento de trabajos científicos en revistas de alto impacto, la capacitación de los técnicos para el diagnóstico adecuado de los parásitos intestinales y la formación de nuevos médicos en esta rama.
(Tomado de Radio Cadena Agramonte)